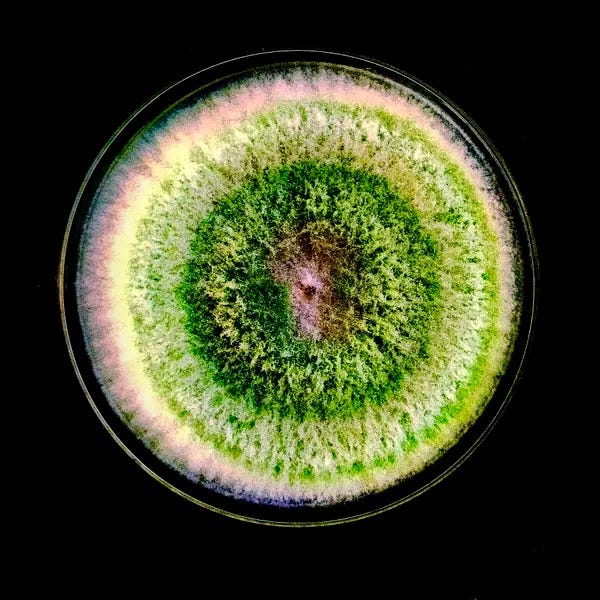
Close up of fungi. Rings of vivid color overlap with one another. The effect is one of an entire world within a single being. Close up of fungi. Rings of vivid color overlap with one another. The effect is one of an entire world within a single being.

So sing.
On soundscapes in the soil which call us to connection
It was probably always going to be fungi who drew me back into this story.
I’ve been away from here for a while. In some ways, away from life. I’ve been… quiet. The kind of ossifying absence of noise that makes you wonder if it’s the world that’s gone silent, or you suddenly can’t hear.
Throughout This Hard Year, I’ve so wanted to come back to writing, but too often that’s felt as preposterous as saying that I wanted to come back to joy.
When I did try to force myself to create—that’s what they tell us, right? true writers come to the desk even when they don’t feel like it—it was not only ineffective, it made things worse. I left each attempt still wordless, but carrying more shame.
Enter the study celebrated in a recent article “Scientists Found a Surprising Way to Make Fungus Happy.” Trichoderma harzianum, an organism vital to soil ecosystems, was grown in two groups: one in an aurally sterilized environment, the other within a soundscape.
“… fungi treated with sound went into overdrive. T. harzianum spores became bright green in color, and the white noise dishes were soon a mossy viridian. By Day 5, the researchers were able to calculate that exposing the fungi to sound had made them grow seven times as fast and produce more than four times as many spores.
‘It might be you can create a certain soundscape that has an invigorating, growth-promoting effect,’ [Dr. Robinson] said.”
Viriditas born from a call, and a response.
Reading the article, I imagine blooms of bright green vibrating in time to the frequency enveloping them. I think of the first explosive song of the Big Bang, still humming through every atom of the universe. I remember learning to swim because my mother first carried me on her back into the pool while singing, so I would feel her in my chest and in the water itself, so I would not be afraid.
As fungi so often do, I am re-taught two essential lessons.
It’s impossible to thrive when perceiving of oneself as an isolated being. We were born not as individuals but nodes, where a vast network intersects momentarily as blood and bone.
To nurture, one must be nurtured.
What makes up the soundscape that calls you to connection?
When this story first called to me, it truly did feel more like a song I was receiving than something I was producing. But I’m not going to now force myself to sit in a quiet box and listen, hoping to hear it once again.
Instead, I’m intentionally re-cultivating the soil, the soundscape I’d rooted into before. Surrounding myself with alive things that call to, and respond to, the aliveness within me.
The vast migration of eels. Mycelium as magic system. Old words for oaks. Land as first and last lover. Free rivers. Humans and spirits who are wonderfully monstrous but not monster.
“In recent years, scientists have put microphones in environments of all kinds, including tropical trees and coral reefs. In the process, they have discovered that an environment’s sound can be linked to its biodiversity — often, the more complex the soundscape, the more diverse and healthy the inhabitants.
Research also shows that playing the sounds of intact ecosystems can help damaged ones recover… the recorded sounds of healthy oyster reefs could lure new oyster larvae to areas destroyed by overfishing.”
And what strains get in the way?
In cultivating this nurturing soundscape, I’ve also been reflecting on which sounds or leitmotifs need to be hushed, or at least better harmonized with.
Maybe I’ve not been living this past year in the absence of sound, but rather a repetitive drone that word count = artistic merit, a dulling hiss that a project which takes years, decades, a lifetime is not worth pursuing, an abrasive chord that, if one more dark eco-romantasy comes out, then there’s no point continuing with this tale.
What makes up the soundscape that calls you to connection? And what strains get in the way?
A parting song.
Shortly before reading this article, I stumbled on a forgotten snippet of diary, from when I was walking in the woods and heard a voice—not my own inner voice, but a voice-that-contained-many-voices, rumbling both within and without me.
I hope this resonates in some small way within your own soundscape.